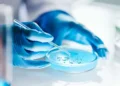

Termo de reciprocidade é assinado na embaixada portuguesa
A Bastonária da Ordem dos Biólogos de Portugal, Maria de Jesus Fernandes, assinou hoje, no dia 3, na Embaixada de Portugal, um Termo de Reciprocidade com a Presidente do CFBio – Conselho Federal de Biologia do Brasil, Alcione de Azevedo, estabelecendo as regras de admissão e o registo de biólogos em Portugal e no Brasil. Um novo e importante passo na mobilidade de profissionais qualificados dos dois países irmãos.
Durante a sua deslocação a Brasília, a Bastonária da Ordem dos Biólogos de Portugal participou igualmente nas celebrações dos 45 anos da regulamentação da profissão de biólogo no Brasil, a convite do CFBio.
Encontra-se igualmente prevista uma visita à Amazónia, onde a Bastonária portuguesa participará em reunião, dia 9 de setembro, na cidade de Manaus, para discutir o tema “O Biólogo Português na Amazónia e o Biólogo Brasileiro em Portugal”.

Senado – Os 45 anos da Lei 6.684, de 1979, que regulamentou a profissão de biólogo no Brasil foram comemorados pelo Plenário do Senado em sessão especial nesta segunda-feira (2). A celebração atendeu a requerimento do senador Hamilton Mourão (Republicanos-RS) e contou com especialistas da área. A solenidade também marcou a fundação do Conselho Federal e dos conselhos regionais de Biologia e Biomedicina, criados pela mesma lei.

Fonte: Embaixada de Portugal